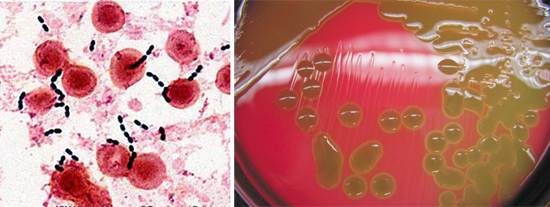

Симптомы
Рожистое воспаление может поражать разные части тела. В 80% заболевание развивается на нижних конечностях, чаще на голени, реже на остальных частях тела.
Общими признаками рожистого воспаления на коже являются:
- Сильное покраснение пораженного участка (эритема), которое несколько возвышается над поверхностью кожи. От здоровых тканей эритема отграничена плотным валиком, однако при распространенной роже его может и не быть;
- Боль при прощупывании области покраснения;
- Отек пораженной области (стопы, голени, лица, предплечья и т.д.);
- Болезненность лимфатических узлов, рядом с очагом инфекции (лимфаденит);
- При буллезной форме, возможно появление прозрачных пузырей на коже, заполненных кровью или серозной жидкостью (плазмой).
Помимо общих признаков, рожа имеет свои особенности при локализации в разных частях тела. Их необходимо учитывать, чтобы вовремя заподозрить инфекцию и своевременно начать лечение.
Резко поднимается температура тела до фебрильных цифр, что сопровождается ознобом, головной болью, слабостью, сердцебиением. У некоторых пациентов на фоне выраженной интоксикации развивается онейроидный или галлюцинаторно-бредовый синдром.
Иногда уже в продромальном периоде отмечаются признаки токсического поражения печени, почек, сердца. Возможны чрезмерная сонливость, тошнота с не приносящей облегчение рвотой.
Местные изменения – основной симптом болезни. При классическом течении они носят локальный характер и четко отграничиваются от соседних участков кожи.
Эритематозная рожа характеризуется появлением резкой яркой гиперемии (эритемы) с четко очерченными краями и даже с небольшим валиком на периферии. Очаг поражения имеет неровные зазубренные границы.
Иногда это напоминает очертания континентов на географической карте. Воспаленная кожа выглядит плотной, отекшей, как бы натянутой и слегка блестящей.
Яркая краснота может сменяться синюшно-застойным оттенком, что связано с нарастающими локальными нарушениями микроциркуляции. Нередко появляются также диапедезные и мелкогеморрагические кровоизлияния, что объясняется пропотеванием и разрывом сосудов.
На 2-3 день заболевания нередко присоединяются признаки лимфостаза с развитием лимфедемы (плотного лимфатического отека). В это же время в пределах очага могут появляться пузыри и пустулы, в этом случае диагностируется буллезная рожа.
Разрешение рожистого воспаления происходит постепенно. При адекватном лечении температура нормализуется в течение 3-5 суток. Острые проявления эритематозной формы исчезают к 8-9 дню, а при геморрагическом синдроме они могут сохраняться в течение 12-16 суток.
Уменьшается отечность и гиперемия кожи, ее поверхность начинает зудеть и шелушиться. У некоторых пациентов после исчезновения основных симптомов отмечается неравномерная гиперпигментация и темная застойная гиперемия, исчезающие самостоятельно.
Но после перенесенной тяжелой буллезно-геморрагической рожи она может сохраняться в течение лет и даже десятилетий.
Стафилококковая палочка свободно обитает в общественных местах, поэтому заболеть рожистым воспалением может каждый. Также высокая вероятность развития заболевания при прямом контакте с больным:
- Инфицирование происходит через повреждённые ткани верхнего слоя эпидермиса. Даже незначительная рана может стать отличной средой для развития воспаления.
- Во время беременности, в периоды болезней, постоянных стрессов и физической нагрузки, нарушается работа иммунной системы, в этот период организм может подвергаться инфицированию.
- Инкубационный период составляет 24 часа.
Важно: Лечение воспаления необходимо начать как можно скорее, если вовремя не обратиться за специализированной помощью, болезнь может стать причиной сепсиса. Основные симптомы:
Основные симптомы:
Также начало заболевания может сопровождаться головными болями, ломотой в мышцах, слабостью, тошнотой, иногда, при острой стадии у пациентов может наблюдаться рвота.
Увеличение лимфатических узлов в местах поражения.
Рожистое воспаление в классическом проявлении выглядит как пораженный участок кожного покрова, обычно ярко розового или красного цвета, имеющий четкие границы, возвышающийся над здоровыми участками тела.
Рожистое воспаление начинается остро. Как правило, человек может указать даже время, когда появились первые симптомы болезни.
Врачи отмечают, что рожа, или эритема, представляет собой острое инфекционное заболевание, вызванное стрептококками. Это заболевание чаще всего проявляется в виде ярко-красных, воспаленных участков кожи, сопровождающихся отеком и болезненностью. Специалисты подчеркивают, что ранняя диагностика и своевременное лечение имеют решающее значение для предотвращения осложнений. Важно помнить, что рожа может возникнуть на фоне других заболеваний, таких как диабет или венозная недостаточность, что требует комплексного подхода к лечению. Врачи рекомендуют соблюдать меры предосторожности, включая соблюдение гигиены и своевременное обращение за медицинской помощью при первых симптомах. Профилактика рожа включает в себя укрепление иммунной системы и контроль за хроническими заболеваниями.
https://youtube.com/watch?v=VqGCB1qj7Iw
Как возникает рожа патогенез рожистого воспаления
Воспаление при рожистом воспалении локализуется чаще всего на лице и голенях, реже на руках, туловище, мошонке, области промежности и слизистых оболочках. Воспалительным процессом при заболевании затрагивается основной слой кожи, ее каркас — дерма. Она выполняет опорную и трофическую функции. В дерме находится множество капилляров и волокон.
Воспаление при роже носит инфекционный и аллергический характер.
- Продукты жизнедеятельности и вещества, выделяемые при гибели бактерий, становятся причиной развития токсикоза и лихорадки.
- Причиной развития воспалительного процесса является воздействие на ткани токсинов, ферментов и антигенов гемолитических стрептококков, а также биологически активных веществ. Повреждаются мелкие артерии, вены и лимфатические сосуды. Воспаление носит серозный или серозно-геморрагический характер.
- Антигены кожи человека по своей структуре схожи со стрептококковыми полисахаридами, что приводит к развитию аутоиммунных процессов, когда антитела больного начинают атаковать свои ткани. Иммунные и аутоиммунные комплексы вызывают поражение кожи и сосудов. Развивается внутрисосудистое свертывание крови, нарушается целостность стенок капилляров, формируется местный геморрагический синдром. В результате расширения сосудов на коже появляется очаг гиперемии и пузырьки, содержимое которых носит серозный или геморрагический характер.
- В кровеносное русло в большом количестве попадают биологически активные вещества, в том числе гистамин, который причастен к развитию геморрагических форм рожистого воспаления.
- Недостаточность лимфообращения проявляется отеками нижних конечностей. Со временем поврежденные лимфатические сосуды замещаются фиброзной тканью,что приводит к развитию слоновости.
- Очаг инфекционно-аллергического воспаления потребляет большое количество глюкокортикоидов. Это приводит к развитию вненадпочечниковой недостаточности. Нарушаются белковый и водно-солевой обмены.
Рис. 6. Воспалительным процессом при заболевании затрагивается основной слой кожи, ее каркас — дерма.
Физиотерапевтические методы лечения рожистого воспаления
Физиотерапия применяется с целью достижения наилучшего эффекта при лечении рожистого воспаления и предотвращения развития нежелательных последствий. В остром периоде применяются такие физиотерапевтические методики, как УФО и УВЧ.
Рожа — это инфекционное заболевание, которое вызывает много обсуждений среди людей. Многие делятся своими историями о том, как они столкнулись с этой болезнью. Чаще всего упоминается, что рожа проявляется внезапно, с яркими симптомами, такими как покраснение и отек кожи. Люди отмечают, что важно не игнорировать первые признаки и сразу обращаться к врачу, так как запущенные случаи могут привести к серьезным осложнениям. В социальных сетях можно встретить советы по профилактике, включая укрепление иммунной системы и соблюдение гигиенических норм. Некоторые делятся опытом лечения, рассказывая о применении антибиотиков и необходимости постельного режима. В целом, обсуждения вокруг рожи подчеркивают важность осведомленности и своевременной медицинской помощи.
Физиотерапия в острый период
- Ультрафиолетовое облучение с использованием коротких волн назначается с первых дней лечения при эритематозной форме заболевания. Под его воздействием стрептококки и стафилококки теряют способность к росту и размножению.
- При УВЧ-терапии используются электромагнитные поля ультравысокой частоты. Тепло, образованное при УВЧ-терапии, проникает глубоко в ткани, способствуя снижению воспаления, отеков, болей и стимуляции кровообращения. Лечение назначается на 5 — 7 день заболевания.
- В остром периоде показано применение криотерапии. Суть криотерапии заключается в кратковременном замораживании поверхностных слоев кожи струей хлорэтила, что приводит к нормализации температуры тела, исчезновению симптомов интоксикации, уменьшению отека и болей в очаге поражения, ускорению процессов репарации.
Рис. 9. В остром периоде применяются такие физиотерапевтические методики, как УФО и УВЧ.
Физиотерапия в восстановительный период
- Инфракрасная лазеротерапия широко применяется при лечении рожистого воспаления, в том числе при геморрагических формах. В стадии выраженного воспалительного отека, геморрагий и появления буллезных элементов показано применение лазерного излучения с низкой частотой, в стадии восстановления — с высокой частотой. Под воздействием лазерного излучения стимулируются процессы кровоснабжения в пораженных участках, активизируются клеточный иммунитет и процессы регенерации.
- Для уменьшения инфильтрата и обеспечения оттока лимфы с 5 — 7 дня заболевания показано применение электрофореза с йодистым калием или лидазой.
- Парафинотерапия, апликации озокерита и повязки с нафталановой мазью при лечении рожи применяется в подострый период, когда еще не развились необратимые процессы на пораженном участке кожи. Парафин используется как теплоноситель. Он медленно отдает тепло, за счет чего расширяются капилляры, усиливается метаболизм в зоне пораженных тканей, ускоряются процессы рассасывания инфильтратов и регенерации.
Апликации озокерита и парафина применяются при локализации рожистого воспаления на лице, повязки с нафталановой мазью показаны при локализации воспаления на нижних конечностях.
В период восстановления показаны радоновые ванны.
Рис. 10. При лечении рожистого воспаления применяются инфракрасная лазеро- и парафинотерапия.
Патогенез
Рожа развивается на фоне иммуногенетической предрасположенности, которая реализуется в сочетании с целым рядом неспецифических экзогенных и эндогенных факторов, приводящих к развитию гиперчувствительности замедленного типа к антигенам стрептококка в определенных участках кожи. Существенное значение имеют: врожденная и приобретенная венозная недостаточность нижних конечностей, хроническая стрептококковая инфекция, грибковая инфекция нижних конечностей, простудный фактор, микротравмы, наличие послеоперационных и посттравматических рубцов, лимфостаз (например, после операции по поводу рака молочной железы). К роже предрасполагают диабет, сердечно-сосудистые заболевания, сопровождающиеся отеками, прием кортикостероидов, цитостатиков.
В очаг поражения возбудитель проникает контактным путем (через микротравмы кожи) или гематогенно-лимфогенным путем при наличии очага стрептококковой инфекции. При отсутствии предшествующей сенсибилизации возникает гнойная инфекция. В условиях специфической сенсибилизации к стрептококку происходит активация медиаторов аллергической воспалительной реакции и развивается картина серозного или серозно-геморрагического воспаления. При этом основной патологический процесс происходит в дерме.
В процесс вовлекаются лимфатические капилляры, сосуды микроциркуляторного русла; формируется воспалительный экссудат, состоящий из лимфоцитов, плазматических клеток и гистиоцитов. Повреждение сосудистой стенки, расстройства микроциркуляции приводят к локальному нарушению гемостаза и геморрагиям. Существенная роль в развитии рожи принадлежит формированию иммунных комплексов и аутоиммунным реакциям. Большое значение в развитии местного процесса и синдрома интоксикации имеют токсины и ферменты возбудителя.
Благодаря фагоцитозу, действию гуморальных факторов жизнедеятельность стрептококка подавляется, происходит его элиминация или формирование его L-форм. После ликвидации острого процесса местная сенсибилизация кожи сохраняется, что приводит к рецидивированию процесса. Повторное развитие процесса сопровождается склерозированием и запустеванием лимфатических сосудов, формированием хронического лимфостаза вплоть до развития слоновости конечностей и половых органов.
При рецидивирующей роже создается хронический очаг эндогенной стрептококковой инфекции. Под влиянием экзогенных и эндогенных факторов наступает его активация. У лиц, страдающих рецидивирующей рожей, наблюдают существенные нарушения в иммунной, нервной и эндокринной системах.
Ющук Н.Д., Венгеров Ю.Я.
Основные пути заражения
Стрептококки чаще всего проникают в организм в местах травм, порезов, даже небольших и неглубоких. Распространены случаи заражения через нестерильные инструменты и материалы для перевязки ран. Некоторую опасность представляют пациенты, страдающие от хронического тонзиллита, вызываемого также стрептококками
Сами пациенты с рожистым воспалением ноги особой опасности для окружающих не представляют, но элементарные меры предосторожности необходимо принимать. Локализоваться очаг может на лице, шее, туловище, но чаще всего – это голень
Для рожистого воспаления не характерно формирование временного или постоянного иммунитета, поэтому некоторые люди болеют больше двух раз. Рожистое воспаление ноги, причины которого напрямую связаны со стрептококками, требует тщательного лечения всех недугов, вызываемых этими бактериями.
Лечение
Лечить рожистое заболевание необходимо и местными и общими методами. Продолжительность лечения этой болезни может проходить от одной недели до нескольких месяцев.
Для излечения данного заболевания зачастую прописывают антибиотики, противовоспалительные средства, витамины, препараты повышающие иммунитет, а также средства, которые снижают проницаемость мелких кровеносных сосудов. Больной рожистым заболеванием обязательно должен пить жидкость в обильных количествах, а также принимать средства, уменьшающие токсическое действие стрептококка.
Местная терапия назначается в виде вспомогательного метода. Его применяют только при обширных пузырьковых поражениях. В качестве местной терапии проводится надсечение пузырьков, вследствие которого они опорожняются. Затем на их места кладут повязки с дезинфицирующими растворами. После стихания острых явлений больному назначают средства, которые стимулируют восстановление тканей.
Терапия
Лечение рожи чаще всего проводят в домашних условиях, но под тщательным наблюдением врача. Больного помещают в стационар только при развитии осложнения. Это часто происходит при наличии воспаления в зоне роста волос на голове или поверхности лица.
Медикаменты
Вылечить рожу довольно легко, если прибегнуть к комплексной терапии с применением нескольких препаратов:
- Антибиотики. Используются в качестве основного препарата, без которого невозможно выздоровление (Амоксиклав, Цефтриаксон, Сульфален). Антибактериальная терапия в среднем длится от 10 до 15 дней.
- Антигистаминные средства. Часто стрептококки на коже запускают реакции, похожие на аллергические. Поэтому прием этих препаратов частично поможет справиться с воспалением, зудом и отечностью (Лоратадин, Клемастин, Тавегил).
- Нестероидные противовоспалительные средства (Нимесил, Кеторолак, Ибупрофен). Помогают справиться с болевым синдромом, снизить температуру тела, избавляют от воспаления.
- Местные средства в виде мазей, присыпок, растворов. Производят обезболивающий, противовоспалительный, антибактериальный эффект. Рекомендуется использовать Фурацилин, Димексид, Энтеросептол, Хлоргексидин.
- В более тяжелых случаях врачи назначают сульфаниламиды, стероидные гормоны, иммуномодуляторы, протеолитические ферменты.
Физиотерапия
Для ускорения выздоровления и снижения доз агрессивных лекарств дополнительно применяется физиотерапия. Ультрафиолетовое излучение, электрофорез, магнитная терапия, лазер или УВЧ помогают улучшить состояние кожи и избавляют от воспалительного процесса. Физиотерапия актуальна для предупреждения новых вспышек рожи, которые наблюдают у четвертой части больных.
Операция
Операция длится недолго и чаще всего под местным обезболиванием. Врач вскрывает гнойники, очищает ткани от гнойного содержимого с последующей антибактериальной терапией для профилактики повторных воспалений.
Народное лечение
Народные методы при не осложненном течении рожи оказываются не менее эффективными, чем медикаментозная терапия. Такие средства рекомендуется сочетать с приписанными врачом препаратами, что произведет лучший эффект.
https://youtube.com/watch?v=Z5AmEacBBDQ
При рожистом воспалении используют следующие лекарства:
- Настой из ромашки и мать-и-мачехи. Травы смешивают в равных пропорциях. На стакан кипятка берут столовую ложку приготовленного сбора. Смесь настаивают на водяной бане в течение 10 минут, после чего охлаждают. Настой используют для обработки всех проблемных участков на теле.
- Мазь из масла шиповника и сока каланхоэ. Ингредиенты смешивают в равных пропорциях и наносят на кожу, когда устранен острый воспалительный процесс. В таких случаях поверхность обычно шелушится, что может стать причиной рецидива заболевания. Мазь увлажнит кожу и устранит раздражение.
- Отвар календулы. Столовую ложку растительного сырья заливают 235 мл кипятка. Смесь охлаждают, после чего используют для обработки воспаленных участков.
- Натуральный крем с увлажняющим и противовоспалительным эффектом. Готовят из домашней сметаны и листьев лопуха, которые необходимо предварительно измельчить. Полученным кремом обрабатывают все проблемные участки утром и вечером.
Успех в большей степени зависит от состояния иммунитета больного. Поэтому для предупреждения рецидивов, которые часто случаются после первого появления рожи, необходимо внимательно следить за своим организмом и вести здоровый образ жизни.
Особенности рожистого воспаление на отдельных участках тела
Чаще всего рожистое воспаление регистрируется на коже нижних конечностей, несколько реже — на верхних конечностях и лице, редко — на туловище, слизистых оболочках, молочной железе, мошонке и зоне промежности.
Рожа на ноге
Рожа на ноге развивается вследствие нарушения целостности кожных покровов, возникновение которой связано с травмами и ушибами. Часто заболевание развивается у больных с грибковым поражением стоп и ногтей на ногах, нарушением кровообращения в нижних конечностях, развившимся в результате сахарного диабета, варикозного расширения вен, курения и избыточного веса. Источником инфекции так же являются очаги хронической инфекции в организме больного.
Чувство жжения, распирающая боль на месте поражения, покраснение и отек — первые признаки и симптомы рожи на ногах.
Рожистое воспаление на ногах чаще носит рецидивирующий характер. Неправильное лечение и наличие очагов хронической инфекции способствуют развитию рецидивирующей формы заболевания.
Частые рецидивы приводят к развитию фиброзных изменений в дерме и подкожной клетчатке с последующим развитием лимфостаза и слоновости.
Рис. 14. На фото рожистое воспаление ног.
Рожистое воспаление на руке
Рожа на руках часто развивается у наркоманов вследствие внутривенного введения наркотиков и у женщин на фоне застоя лимфы, как следствия перенесенной радикальной мастэктомии.
Рис. 15. Рожа на кистях рук.
Рис. 16. На фото рожистое воспаление руки.
Рожа на лице
Чаще всего на лице возникает первичная эритематозная форма рожистого воспаления. Покраснение часто захватывает область щек и носа (по типу бабочки) и, кроме отека и зуда, часто сопровождается сильными болями. Иногда очаг воспаления распространяется на все лицо, волосистую часть головы, область затылка и шеи. У части больных заболевание осложняется развитием абсцессов в толще век и скоплением гноя под волосистой частью головы. При распространении инфекции в подкожную жировую клетчатку развивается флегмона. У ослабленных лиц и стариков может развиться гангрена.
Источником инфекции при рожистом воспалении на лице часто является стрептококковая инфекция пазух носа и фурункулы. Источником инфекции при рожистом воспалении глазницы является стрептококковый конъюнктивит.
При стрептококковом отите иногда развивается рожистое воспаление ушной раковины, нередко воспалительный процесс распространяется на волосистую часть головы и шею.
Рис. 17. На лице чаще возникает эритематозная форма рожистого воспаления.
Рис. 18. Рожа на лице. Покраснение часто захватывает область щек и носа (по типу бабочки).
Рис. 19. Иногда очаг воспаления распространяется на все лицо, волосистую часть головы, область затылка и шеи.
Рис. 20. На фото рожистое воспаление руки.
Рожистое воспаление туловища
Рожистое воспаление иногда развивается в области хирургических швов при несоблюдении правил асептики. Тяжело протекает рожа при проникновении стрептококков в пупочную ранку новорожденного. Рожистое воспаление молочной железы развивается на фоне мастита. Развитие гангрены может привести к рубцеванию с последующим нарушением функции органа.
Рожа половых органов и промежности
При роже мошонки, полового члена, женских половых органов и промежности чаще всего развивается эритематозная форма заболевания с резко выраженным отеком подлежащих тканей. Развившийся некроз ткани с последующим рубцеванием приводит к атрофии яичек. Рожа у рожениц протекает крайне тяжело. Воспалительный процесс часто затрагивает внутренние половые органы.
Рожистое воспаление слизистых оболочек
При рожистом воспалении слизистых оболочек чаще поражаются зев, гортань, полость рта и слизистая оболочка носа. При поражении слизистых оболочек развивается эритематозная форма заболевания. В области воспаления развивается гиперемия и значительный отек, нередко с очагами некроза.
Рис. 21. На фото рожистое воспаление слизистой оболочки полости рта.
Консультации ВРАЧА онлайн
Пациент: Добрый вечер! Ответьте пожалуйста, какие еще заболевания могут быть по внешнему воспалению голени похожи на рожу? У меня была сухая красная кожа с четкими границами внизу и вверхуВрач: Ольга, кроме рожи похожим образом может проявляться сахарный диабет. Поэтому обязательно сдать общий анализ крови и кровь на сахарПациент: просто удивительно, если никогда ни у кого таких проявлений не было, откуда тогда могло появиться у меня? если везде написано, что рожа заразительная болезньЯ регулярно прохожу обследования, в первую очередь кровь, и никаких проявлений в крови нет, ни на сах. диабет, ни на стрептококкиВрач: Как давно у Вас проявления на голени? Сколько Вам лет? И когда в последний раз сдавали анализы?Пациент: у меня такое проявление было года три назад, мне сейчас 64, анализ профилактического осмотра, по его результатам мне врач сказала, что у меня все в порядке, я сдавала в июне э. г.Но вопрос возник, потому что сейчас моя сестра сказала, что у нее тоже воспалились обе голени и пытается выяснить, что это может быть. И пугает меня, что это и у нее и у меня — рожа.Врач: А сестра обследовалась сейчас?Пациент: нет, она вообще не хочет ходить ко врачам, и ей почти 77 летВрач: А на дом у Вас вызова врача нет? Никто из домашних и соседей не болеет ангиной?Пациент: мне врач не нужен, сейчас проблема с сестрой и проблема та, что ее никуда не выгонишь, ни домой она врача не хочет. насколько я знаю, у них никого нет с ангиной в настоящий моментВрач: Просто стрептококком можно заразиться не только при контакте с больным рожей, но и от больного классической ангиной человека.В любом случае, сложно поставить диагноз не видя пациента и не имея его анализов.Врач: это понятно и логично, но просто я пытаюсь выяснить, что может быть еще за проблема, кроме рожи. Напр. когда у меня было это воспаление при абсолютном отсутствии каких либо других симптомов, мне врач сказал, что надо попить лекарства на сосудистые заболевания — Венорутон, Аскорутин. С тех пор у меня ничего подобного не было. Венорутон пью регулярно и из-за других симптомов.Пациент: Но тогда кожа воспалилась на другой день после моего возвращения из Турции, я подумала, что это от долгого сидения без движения в самолете. А может быть и из-за перепадов температур?Пациент: Извините, просто еще вопрос, надо мне провериться еще каким=то специальным анализом крови или какой делается при профилактике достаточно?Врач: Видите ли в чем дело, не обязательно очаг покраснения кожи — это обязательно воспаление.Пациент: Не поняла, т.е. может быть покраснение не признаком воспаления? А тогда что это может значить? т.е. просто что это другое заболевание? не проявление рожи? Вобщем, я поняла что надо сходить попросить сдать анализ именно на стрептококки?или если сейчас у меня нет проявлений, анализ сейчас может ничего не показать?Врач: Если у Вас сейчас нет проявлений, то ни один анализ ничего не покажет. Он покажет только если Вы уже болеете.Конечно, хорошо бы все-таки определиться, чем именно болеет Ваша сестраВидимо у Вас 3 года назад были проявления не рожи, а венозной недостаточности.Не исключено, что ее состояние тоже носит какой-то иной характерПациент: спасибо! я постараюсь ее уговорить сходить ко врачу. По своему состоянию я так и думала. Еще раз спасибо.Врач: Не болейте!Пациент: спасибо! и Вы! и поменьше работы!
***************
Похожие интересные статьи:
Невралгия тройничного нерва: симптомы и лечение
Крапивница: причины, симптомы и основы лечения
Болезни потовых желез: симптомы и разновидности патологий
Герпес – болезнь навсегда
Профилактика рожи
Перечень профилактических мероприятий после выздоровления
- Лечение заболеваний, способствующих развитию рожистого воспаления — хронической венозной недостаточности, лимфостаза, и ногтей, очагов хронической стрептококковой инфекции.
- Предупреждение микротравм кожных покровов и обработка антисептиками при их возникновении.
- При рецидивирующем течении проводить профилактику бициллином-5 (признается не всеми), избегать переохлаждений, своевременно проходить курс лечения антибиотиками.
Как избежать заболевания
- Соблюдать правила личной гигиены.
- Проводить профилактику и своевременно лечить опрелости.
- Обрабатывать антисептиками повреждения кожных покровов.
- Бороться с очагами хронической инфекции, в том числе с микозом стоп и ногтей.
- Лечить заболевания, способствующие развитию рожистого воспаления.
Рис. 13. Лимфостаз и варикозное расширение вен нижних конечностей способствуют появлению рожистого воспаления.
ССЫЛКИ ПО ТЕМЕ
- Все про противобактериальные препараты
- Что такое экзема?
- Все о профилактике педикулеза
- Что такое гемолитический стрептококк
- Рожистое воспаление на ноге
- Фото стрептококков
- Лечение педикулеза домашних условиях
- Антисептики для обработки рук
- Что такое опрелости
Статьи раздела «Рожистое воспаление (рожа)»
- Вопросы диагностики, лечения и профилактики рожистого воспаления
Самое популярное
- Все о грибке стопы: симптомы и эффективное лечение современными препаратами
- Грибок кожи головы: как распознать и лечить
- Симптомы и лечение грибка ногтей на руках (онихомикоза)
- Польза и вред кишечной палочки
- Как лечить дисбактериоз и восстановить микрофлору
Статьи раздела «Рожистое воспаление (рожа)»
- Вопросы диагностики, лечения и профилактики рожистого воспаления
О микробах и болезнях 2019
История и распространение
Болезнь известна с древности. Впервые о ней упоминается в папирусе Эберса (3730—3710 гг. до н.э.). Гиппократ (460—377 гг. до н.э.) описывает рожу под названием «Erysipelas» — красная кожа. Описания рожи дают Цельсий, Гален, Авиценна. Стрептококковая этиология была экспериментально доказана в 1883 г. Фелейзеном. Длительная дискуссия о наличии специфического «рожистого» стрептококка закончилась признанием того факта, что болезнь может быть вызвана любым штаммом бета-гемолитического стрептококка группы А. В прошлом до разработки современных принципов асептики и антисептики рожа была частым заболеванием среди раненых и рожениц. В настоящее время рожа встречается практически во всех регионах мира и относится к числу распространенных болезней. Заболеваемость в России колеблется от 100 до 250 на 100 000 населения в год.
Лабораторная диагностика рожи
Оптимальным методом при диагностике рожистого воспаления является обнаружение возбудителя заболевания и определения его чувствительности к антибиотикам, что, несомненно, значительно улучшает эффективность лечения. Однако, несмотря на то, что в пораженной зоне скапливается огромное количество стрептококков, выявить возбудителей удается только в 25% случаев. Это связано с воздействием на бактерии антибактериальных препаратов, которые быстро останавливают рост возбудителей рожистого воспаления, поэтому использование бактериологического метода считается нецелесообразным.
- Бактериологические метод исследования применяется в случае затруднения постановки диагноза. Материалом для исследования является содержимое язв и ран. Используется методика отпечатка, когда предметное стекло прикладывается к пораженному участку. Далее мазок изучается под микроскопом.
- Свойства бактерий и их чувствительность к антибиотикам исследуются при росте на питательных средах.
- Специфические методы лабораторной диагностики рожи не разработаны.
- В крови больных с рожистым воспалением, как и при всех инфекционных заболеваниях, отмечается повышенное количество лейкоцитов, нейтрофильных гранулоцитов и повышение СОЭ.
Рис. 6. На фото слева стрептококки под микроскопом. Бактерии располагаются цепочками и попарно. Справа — колонии стрептококков при росте на питательных средах.
Осложнения
Любая рожистая инфекция, при несвоевременно начатом лечении или значительно ослабленном организме больного, может привести к следующим осложнениям:
К наиболее вероятным осложнениям рожи относятся:
- обширная флегмона или абсцесс;
- тромбофлебит близлежащих вен;
- инфекционно-токсический шок;
- сепсис;
- ТЭЛА;
- артриты;
- тендовагиниты;
- миокардит;
- нефрит, гломерулонефрит;
- острый инфекционный психоз.
Если лечение рожи было выполнено своевременно, осложнения встречаются довольно редко. Группу риска их проявления составляют люди пожилого возраста и лица с ослабленным иммунитетом. К осложнениям относятся:
- нарушения кровообращения;
- почечная недостаточность;
- воспаление бронхов;
- образования тромбов;
- формирование слоновости;
- появление на коже язв, некрозов и абсцессов;
- заражение крови;
- застой лимфы.
При неправильном лечении болезнь может вызвать ряд осложнений:
В основном лечение рожистого воспаления амбулаторное
При правильном лечении рожа на руке, спустя 2-3 недели, может пройти самостоятельно. Краснота и отечность пойдут на спад и вскоре пройдут вовсе. Но может остаться пигментация. Возможны рецидивы.
Новое рожистое воспаление впоследствии может привести к:
- застою лимфы;
- недостаточности лимфообращения;
- тромбоэмболии легочной артерии;
- сепсису;
- омертвению кожи;
- тромбофлебиту.
К осложнениям, как правило, приводит несвоевременное обращение к врачам, самолечение, присоединение вторичной инфекции. В группу риска входят люди с сахарным диабетом, ВИЧ-инфицированные, переболевшие менингитом, пневмонией.
Рожистое воспаление с осложнениями может привести к образованию трофических язв на руке, лимфостазу, абсцессу, нагноение и утолщению кожи что значительно усложнит лечение, и даже может поставить под угрозу жизнь самого больного.
Самые распространенные осложнения рожи:
- абсцесс;
- флегмона;
- язвенные дефекты тканей;
- лимфостаз конечностей, в тяжелых случаях — слоновость;
- гиперкератоз на пораженном участке;
- пневмония;
- сепсис.
https://youtube.com/watch?v=videoseries
Лечение рожистого воспаления и физиотерапия
Лечение рожистого воспаления
Рожистое воспаление ноги предполагает госпитализацию пациента. Причем не потому, что он опасен для окружающих, это совсем не так. Заболевание достаточно коварно и лечить его следует под строгим присмотром специалистов. Кроме того, в условиях стационара врач назначит физиотерапевтические процедуры, например, ультрафиолетовое облучение и кварц, губительные для возбудителя.
Основу лечения составляют антибактериальные препараты, против которых у возбудителя нет резистентности. Антибиотики при рожистом воспалении ноги не принимают меньше 7 дней, чаще показан десятидневный курс. Эффективна местная терапия — обработка пораженного участка эритромициновой мазью или измельченными таблетками. Если доктор сочтет нужным, он порекомендует средства народной медицины, которые можно использовать с традиционными препаратами, и которые помогут облегчить состояние.
Иногда врач назначает противовоспалительные или антигистаминные препараты, но не всегда, так как считается, что это тормозит лечение и снижает его эффективность. Пациенту показано обильное питье.
Тяжелые формы заболевания требуют комплексного лечения, направленного на защиту сердца и поддержание его работы. Применяются витамины, гамма-глобулин, биостимуляторы. Может возникнуть необходимость в переливании крови и плазмы. Частые рецидивы требуют назначения гормональных препаратов.
Z8uollrC6ME
В большинстве случаев, если у пациента диагностируют рожистое воспаление ноги, лечение проходит успешно, главное, своевременно обратиться за помощью и не использовать запрещенных в данном случае препаратов. Очень часто попытки самолечения заканчиваются плачевно из-за распространенного метода – прикладывания к пораженному участку мази Вишневского. Из-за этого экссудация усиливается и заживление затягивается.
Терапевтические методы в лечении рожи
Терапевтический курс при лечении рожистого воспаления обычно составляет от недели до десяти дней, а больных рекомендуется госпитализировать во избежание последствий разной степени тяжести и значительного ухудшения самочувствия.
Изоляция пациентов считается необходимой даже при легкой форме болезни. При роже крайне не рекомендуются разовые и двукратные инъекции пенициллина в сутки, даже если речь идет о сравнительно крупных дозах.
В основе лечения лежит рациональная антибиотикотерапия, а в качестве дополнительных средств используются дезинтоксикационные препараты.
Лечение антибиотиками начинается сразу после положительной реакции организма пациента на проведенную антибиотикотерапию. В подобном случае за сутки озноб и лихорадка исчезают, воспалительные процессы стухают, а интенсивность болевых ощущений уменьшается.
Пересмотр диагноза или определение степени тяжести болезни стоит проводить лишь после отсутствия улучшений по прошествии 72 часов после введения антибиотиков.
- В 80% случаев бензилпенициллин оказывает положительное действие, если речь не идет о наличии сепсиса или других инфекций;
- При аллергии на стандартные пенициллиновые препараты рекомендуется использовать макролиды;
- Антимикотики используются при роже ноги, осложненной развитием грибка;
- Язвенные поражения требуют лечения только антибиотиками системного характера;
- Использование любых антибиотиков при рожистом воспалении не исключает возможность рецидивов.
В отличие от других последствий, вероятность возникновения тромбов при роже незначительная, так что антикоагулянты обычно не используются. В случае, когда рожистое воспаление осложняется варикозом или ожирением, рекомендуется профилактика тромбоза глубоких вен с помощью гепариновых инъекций.
Рецидивы рожи могут возникнуть, если не была устранена первопричина заболевания (провоцирующие факторы). Интересно, что повторное развитие воспалительных процессов может локализоваться на другом участке, иногда довольно далеком от первого.
Обработка антисептиками даже мелких повреждений кожного покрова является весьма эффективной профилактической мерой против возникновения рожи, для этого можно использовать специальные гели в том числе.
Стоит запомнить, что народные лекарства – мази, травы и настои, не помогут в борьбе с болезнью, и могут использоваться лишь в качестве вспомогательного средства после консультации с лечащим врачом.
Вопрос-ответ
Откуда берется болезнь рожа?
Причины. Рожистое воспаление вызывается стрептококками — а точнее, одной из разновидностей бактерий данной группы. В организме с ослабленным иммунитетом стрептококк способен вызывать и другие заболевания — например, скарлатину, миокардит, ангину. Около 15% людей планеты являются носителями стрептококка.
Как можно подхватить рожу?
Причины появления рожистого воспаления. Возможен контактный, аэрозольный и воздушно-капельный пути передачи инфекции. Занос возбудителя на кожу происходит через руки из первичного источника инфекции (например, из носоглотки) при наличии любых (даже минимальных) нарушений целостности кожного покрова.
Можно ли заразиться рожей от другого человека?
Рожистая инфекция является малоконтагиозной, то есть заражение от больного человека происходит достаточно редко.
Сколько дней длится рожа?
Местные проявления рожи исчезают через 10—14 дней после начала болезни, однако пастозность и пигментация кожи при этом могут длительно сохраняться. В некоторых случаях регионарный лимфаденит и инфильтрация кожи сохраняются долго, что свидетельствует о риске раннего рецидива рожи.
Советы
СОВЕТ №1
Обратитесь к врачу при первых симптомах. Рожа может проявляться в виде покраснения, отека и болезненности кожи. Не откладывайте визит к специалисту, так как раннее лечение поможет избежать осложнений.
СОВЕТ №2
Следите за гигиеной кожи. Регулярное мытье и уход за кожей помогут предотвратить инфекции, которые могут привести к развитию рожи. Используйте мягкие моющие средства и избегайте травмирования кожи.
СОВЕТ №3
Принимайте назначенные врачом антибиотики. Лечение рожи обычно включает антибиотики, которые помогают устранить инфекцию. Не прекращайте курс лечения раньше времени, даже если симптомы исчезли.
СОВЕТ №4
Укрепляйте иммунную систему. Здоровый образ жизни, включая сбалансированное питание, регулярные физические нагрузки и достаточный сон, поможет вашему организму лучше справляться с инфекциями и снизит риск возникновения рожи.